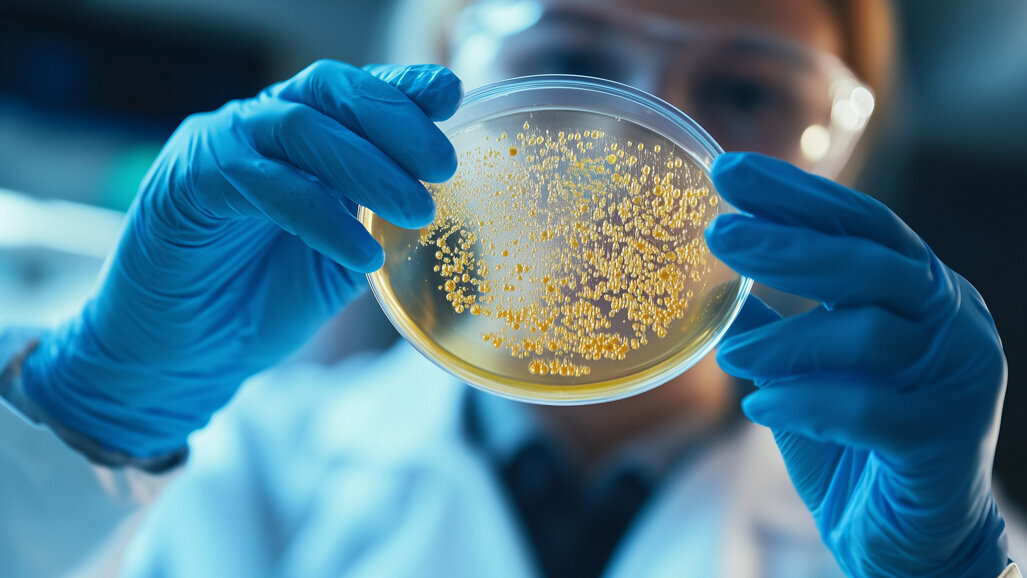
Mikrobiom-Forschung: Speicheltypen als möglicher Risikoindikator

Hohenheim – Eine einfache Speichelprobe könnte künftig wertvolle Hinweise auf die Zusammensetzung des Magen- und Dünndarm-Mikrobioms liefern – und damit helfen das individuelle Risiko für bestimmte Erkrankungen abzuschätzen.
Zu diesem Schluss kommt eine Untersuchung der Universität Hohenheim in Stuttgart. Die Forschenden zeigen, dass sich das Mikrobiom des oberen Verdauungstrakts zuverlässig über Speichelproben charakterisieren und Menschen verschiedenen Mikrobiomtypen zuordnen lassen.
Besonders auffällig ist ein Mikrobiomtyp, der von der Bakteriengattung Prevotella-7 dominiert wird: Personen mit diesem Profil weisen weniger potenziell krankmachende Bakterien und niedrigere Werte des Entzündungsmarkers TNF-α auf, der eine zentrale Rolle bei vielen chronisch-entzündlichen Erkrankungen spielt.
Das orale Mikrobiom, also die Gesamtheit aller Bakterien im Mundraum spielt eine zentrale Rolle für die Gesundheit eines Menschen: Es beeinflusst das Risiko und den Verlauf zahlreicher Erkrankungen von der Mundhöhle bis zur Speiseröhre und dem Magen sowie von Entzündungen im Darm und Infektionen der Atemwege und des Herzens (Endokarditis). Es kann als Reservoir für Erreger dienen, die für gesunde Menschen harmlos sind, aber bei Personen mit geschwächtem Immunsystem schwere Krankheiten auslösen können.
„Das Mikrobiom von Magen und Dünndarm ist jedoch noch verhältnismäßig unerforscht“, so W. Florian Fricke, Professor am Fachgebiet Mikrobiom und Angewandte Bioinformatik. „Um Proben aus Magen und Dünndarm zu nehmen, müssen sich Patient:innen oder Studienteilnehmer:innen einer aufwendigen und unangenehmen Magenspiegelung unterziehen. Viel einfacher und unkomplizierter lassen sich Speichelproben aus dem Mund gewinnen“, erklärt der Experte.
Enge Verbindung zwischen Mund- und Dünndarmmikrobiom
In einer Studie mit 20 Personen, die sich wegen leichter nahrungsmittelbedingter Magen-Darm-Beschwerden einer Magenspiegelung unterziehen mussten, konnten die Forschenden zwei stabile Mikrobiomtypen in Speichel, Magen und Dünndarm identifizieren. Diese bakteriellen Gemeinschaften waren bei den betreffenden Personen vom Mundraum bis in den Magen und Dünndarm konstant und wurden von jeweils einer Bakteriengattung dominiert.
Bestätigen konnten die Forschenden diese Ergebnisse an einem öffentlich zugänglichen Datensatz von 254 Menschen, die an der sogenannten REIMAGINE-Studie teilnahmen. Dabei handelt es sich um eine groß angelegte Forschungsinitiative des Cedars-Sinai Medical Center in den USA, die sich mit der Zusammensetzung und Funktion des Dünndarm-Mikrobioms bei Gesundheit und Krankheit des Menschen beschäftigt.
Besonders interessant ist der Speichel-Mikrobiomtyp, in dem die Bakteriengattung Prevotella-7 vorherrscht. Teilnehmende beider Studien mit diesem Profil wiesen geringere Mengen potenziell krankmachender Bakterien auf, darunter Arten, die mit Endokarditis (Herzinnenhautentzündung) oder Darmkrebs in Verbindung stehen.
Außerdem hatten sie niedrigere Werte des Entzündungsmarkers TNF-α im Blut. Da dieses Protein als Zytokin bei vielen chronisch-entzündlichen und Autoimmunerkrankungen eine wichtige Rolle spielt, könnte das auf ein insgesamt geringeres Risiko für Entzündungen und Infektionen bei Menschen mit diesem Mikrobiomtyp hinweisen.
Präzise Analysen trotz geringer Bakterienzahl
Die Ergebnisse basieren auf einem neu entwickelten Verfahren, mit dem sich auch aus den vergleichsweise bakterienarmen Proben aus Speichel, Magen und Zwölffingerdarm verlässliche Aussagen über das Mikrobiom ableiten lassen. „Aufgrund der geringen Bakterienzahl kann schon ein geringer Eintrag von Bakterien, die nahezu überall in der Umwelt und im Labor vorkommen, bei der Aufarbeitung der Proben zu Verunreinigungen führen, die die Ergebnisse stark verfälschen“, erklärt Doktorandin Nina Schmidt die Problematik. Um die Zuverlässigkeit der Ergebnisse zu gewährleisten, schloss das Forschungsteam deshalb mögliche Verunreinigungen durch strenge Kontrollen in allen Arbeitsschritten aus.
Grundlage für ihre Analysen ist das Erbgut der Bakterien. „Wir nutzten eine Kombination aus DNA und RNA, die sich in den Proteinfabriken der Zelle, den Ribosomen, befindet. RNA kann nur aus aktiven, lebensfähigen Mikroben isoliert werden“, beschreibt die Wissenschaftlerin das Vorgehen. „So können wir zum Beispiel aktive Bakterienarten im Dünndarm von toten, verschluckten und inaktiven Bakterien aus dem Mund oder der Nahrung unterscheiden und die Zusammensetzung der relevanten bakteriellen Gemeinschaften in Magen und Dünndarm besser beschreiben.“
Einfaches Instrument zur individuellen Vorhersage von Risiken
„Unsere Ergebnisse deuten darauf hin, dass Speichelproben künftig in nicht-invasiven und regelmäßig wiederholbaren diagnostischen Tests eingesetzt werden könnten, um das individuelle Risiko für bestimmte entzündliche und infektiöse Erkrankungen abzuschätzen“, fasst Professor Fricke die Erkenntnisse zusammen.
„Eine solche Diagnostik könnte in der klinischen Praxis helfen, Risikogruppen frühzeitig zu identifizieren und gezielte Präventionsmaßnahmen, zum Beispiel prophylaktische Antibiotikabehandlungen, einzuleiten. Angesichts der leichten Handhabung und geringen Belastung für die Patient:innen könnten sich damit neue Wege für Speicheltest-basierte personalisierte Mikrobiom-Untersuchungen zur Prävention, Früherkennung und Beobachtung von Erkrankungen eröffnen“, schlägt der Experte vor.
Weitere Informationen:
Publikation: Schmidt, N. S., Dörner, E., Podlesny, D., Bohlhammer, E., Bubeck, A. M., Ruple, H. K., Tetzlaff-Lelleck, V., Sina, C., Schmidt, H., Fricke, W. F. (2025). Contamination-controlled upper gastrointestinal microbiota profiling reveals salivary-duodenal community types linked to opportunistic pathogen carriage and inflammation. Gut Microbes, 17(1). https://doi.org/10.1080/19490976.2025.2539452
Schlagwörter:
São Paulo – Ein Naturstoff aus Pflanzen wie Guavenblättern, Äpfeln, Zwiebeln und Feigen könnte vielleicht eines Tages eine neue Waffe gegen ...
Köln – Ein systematischer Review mit Metaanalyse über 9 Studien zeigte vielversprechende Ergebnisse für einen Beitrag der mediterranen Ernährung zur ...
Abu Dhabi – Die Mundhöhle ist ein komplexes mikrobielles Ökosystem. Mehrere hundert Bakterienarten besiedeln Zähne, Schleimhäute und Zunge und stehen ...
CHICAGO, USA – Der Zusammenhang zwischen Parodontitis und Alzheimer war schon häufig Gegenstand wissenschaftlicher Forschungen.
BERN – Zwei Forschungsteams aus Bern und Zürich haben eine neue Methode entwickelt, um einen Einblick in einen bislang kaum erforschten Teil der ...
Freiburg – Im Mund leben tausende verschiedene Bakterien, viele davon sind bislang unbekannt. Forscher*innen des Universitätsklinikums Freiburg wollen ...
KLAGENFURT – Ein Wirtschaftswissenschaftler legt in einer Forschungsarbeit die Probleme des österreichischen und deutschen Gesundheitssystems ...
BOSTON, USA – Wissenschaftler der Harvard T.H. Chan School of Public Health und der Icahn School of Medicine at Mount Sinai fanden in einer Studie ...
L’Aquila – Geschlechtsspezifische Medizin erlebt in den letzten Jahren große Aufmerksamkeit. Forschungen machen immer deutlicher, dass viele ...
Chicago – Wer schon einmal beim Eisessen zusammengezuckt ist, kennt das Problem: Plötzlicher Schmerz, der tief in den Zahn zieht. Die Ursache liegt im ...
Live-Webinar
Di. 23. Juni 2026
2:00 Uhr CET (Berlin)
Live-Webinar
Di. 23. Juni 2026
19:00 Uhr CET (Berlin)
Live-Webinar
Di. 23. Juni 2026
21:00 Uhr CET (Berlin)
Live-Webinar
Mi. 24. Juni 2026
14:00 Uhr CET (Berlin)
Live-Webinar
Mi. 24. Juni 2026
17:00 Uhr CET (Berlin)
Live-Webinar
Mi. 24. Juni 2026
18:30 Uhr CET (Berlin)
Dr. med. dent. Britta Hahn
Live-Webinar
Do. 25. Juni 2026
20:00 Uhr CET (Berlin)
Dr. Hatem Algraffee, Cat Edney



 Österreich / Österreich
Österreich / Österreich
 Bosnien und Herzegowina / Босна и Херцеговина
Bosnien und Herzegowina / Босна и Херцеговина
 Bulgarien / България
Bulgarien / България
 Kroatien / Hrvatska
Kroatien / Hrvatska
 Tschechien & Slowakei / Česká republika & Slovensko
Tschechien & Slowakei / Česká republika & Slovensko
 Frankreich / France
Frankreich / France
 Deutschland / Deutschland
Deutschland / Deutschland
 Griechenland / ΕΛΛΑΔΑ
Griechenland / ΕΛΛΑΔΑ
 Ungarn / Hungary
Ungarn / Hungary
 Italien / Italia
Italien / Italia
 Niederlande / Nederland
Niederlande / Nederland
 Nordic / Nordic
Nordic / Nordic
 Polen / Polska
Polen / Polska
 Portugal / Portugal
Portugal / Portugal
 Rumänien & Moldawien / România & Moldova
Rumänien & Moldawien / România & Moldova
 Slowenien / Slovenija
Slowenien / Slovenija
 Serbien & Montenegro / Србија и Црна Гора
Serbien & Montenegro / Србија и Црна Гора
 Spanien / España
Spanien / España
 Schweiz / Schweiz
Schweiz / Schweiz
 Türkei / Türkiye
Türkei / Türkiye
 Großbritannien und Irland / UK & Ireland
Großbritannien und Irland / UK & Ireland
 International / International
International / International
 Brasilien / Brasil
Brasilien / Brasil
 Kanada / Canada
Kanada / Canada
 Lateinamerika / Latinoamérica
Lateinamerika / Latinoamérica
 USA / USA
USA / USA
 China / 中国
China / 中国
 Indien / भारत गणराज्य
Indien / भारत गणराज्य
 Pakistan / Pākistān
Pakistan / Pākistān
 Vietnam / Việt Nam
Vietnam / Việt Nam
 ASEAN / ASEAN
ASEAN / ASEAN
 Israel / מְדִינַת יִשְׂרָאֵל
Israel / מְדִינַת יִשְׂרָאֵל
 Algerien, Marokko und Tunesien / الجزائر والمغرب وتونس
Algerien, Marokko und Tunesien / الجزائر والمغرب وتونس
 Naher Osten / Middle East
Naher Osten / Middle East

To post a reply please login or register